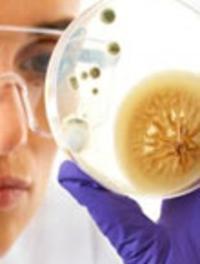

Actualités en infectiologie
Réunion Interdisciplinaire en Chimiothérapie Anti-Infectieuse
Du 27/11/2014 au 28/11/2014
- Paris
C'est à Paris, que s'est tenu les 27 et 28 novembre dernier, la Réunion Interdisciplinaire en Chimiothérapie Anti-Infectieuse (RICAI).